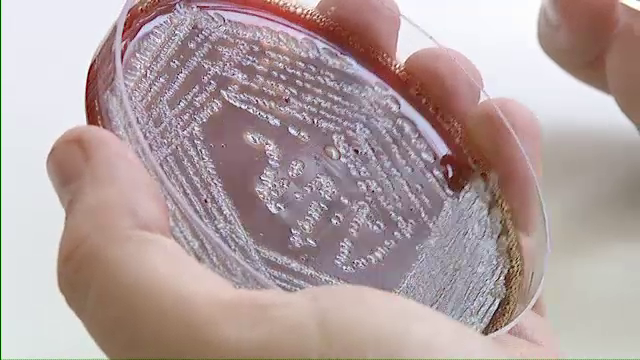

Ministerul Sanatatii anunta marea vanatoare de GANDACI. Cand incep raziile prin spitalele Romaniei
Adio, gandaci din spitale! Cel putin asa ar trebui sa stea lucrurile de la 1 martie, cand toate spitalele de stat vor fi controlate drastic la capitolul curatenie.
Masura luata de Ministerul Sanatatii vine dupa cifre ingrijoratoare, care arata ca din ce in ce mai multi romani se aleg cu infectii in institutiile sanitare, publice.
Conform statisticilor, aproximativ 10.000 de romani se imbolnavesc anual din cauza bacteriilor din spitale.
Controlul, care va incepe in luna martie, se va finaliza in mai, iar in luna iunie vor fi facute publice primele rezultate ale anchetei.
In vara anului trecut, un barbat in varsta de 56 de ani a decedat, dupa ce s-a ales cu o infectie de la Spitalul Judetean din Timisoara. Bacteria ucigasa, "clostridium difficile", rezistenta la antibiotice, se transmite de la un pacient deja infectat la unul sanatos, sau prin contactul direct cu lenjeria, mobilierul sau cu obiectele din spital.
Tot in anul 2013, in luna februarie, un focar de infectie a fost depistat la Spitalul de Pediatrie din Ploiesti, unde o ruda a unui pacient, a filmat cum misunau gandacii prin paturile copiilor si pe instrumentarul medical.